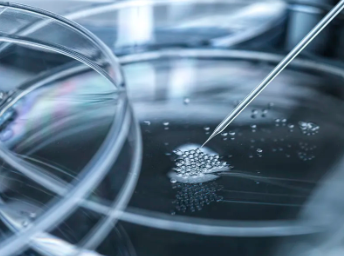
image.png

干細(xì)胞公司排名如何?哪家公司實(shí)力領(lǐng)先?
2024-10-23 10:36:22 來源: 小編 咨詢醫(yī)生
隨著生物科學(xué)技術(shù)的不斷發(fā)展,干細(xì)胞研究逐漸成為我國乃至全球生物技術(shù)領(lǐng)域的熱點(diǎn)。干細(xì)胞治療作為一種具有廣泛應(yīng)用前景的生物療法,吸引了眾多企業(yè)和投資者關(guān)注。那么,在眾多干細(xì)胞公司中,哪家公司排名靠前,實(shí)力領(lǐng)先呢?以下是一些在干細(xì)胞領(lǐng)域具有較高知名度和競爭力的公司。
1.通策醫(yī)療
通策醫(yī)療是我國干細(xì)胞行業(yè)的領(lǐng)軍企業(yè)之一,公司專注于干細(xì)胞技術(shù)的研究與臨床應(yīng)用。通策醫(yī)療在干細(xì)胞治療領(lǐng)域擁有豐富的技術(shù)儲備和專利,涵蓋了多種疾病的治療方法。此外,公司還與國內(nèi)外多家知名科研機(jī)構(gòu)和醫(yī)院建立了緊密的合作關(guān)系,為干細(xì)胞技術(shù)的研發(fā)和臨床轉(zhuǎn)化提供了有力保障。
2.華潤三九
華潤三九是一家集藥品研發(fā)、生產(chǎn)、銷售為一體的大型制藥企業(yè)。在干細(xì)胞領(lǐng)域,華潤三九通過收購、合作等方式,積極布局干細(xì)胞產(chǎn)業(yè)。公司已成功研發(fā)出多款干細(xì)胞產(chǎn)品,并在臨床應(yīng)用方面取得了顯著成果。憑借強(qiáng)大的技術(shù)實(shí)力和資源整合能力,華潤三九在干細(xì)胞行業(yè)具有較高的競爭力。
3.中源協(xié)和
中源協(xié)和是一家專注于干細(xì)胞技術(shù)研究和產(chǎn)業(yè)化的高新技術(shù)企業(yè)。公司主要從事干細(xì)胞存儲、研發(fā)、臨床應(yīng)用等業(yè)務(wù),擁有完整的干細(xì)胞產(chǎn)業(yè)鏈。中源協(xié)和在干細(xì)胞領(lǐng)域擁有多項(xiàng)核心技術(shù),并在全球范圍內(nèi)進(jìn)行了廣泛的合作與交流。公司憑借在干細(xì)胞行業(yè)的深耕細(xì)作,已發(fā)展成為國內(nèi)干細(xì)胞產(chǎn)業(yè)的佼佼者。
4.國際干細(xì)胞療法公司
國際干細(xì)胞療法公司(Cytori Therapeutics)是一家**干細(xì)胞治療企業(yè),專注于開發(fā)基于自體脂肪來源的干細(xì)胞治療產(chǎn)品。公司已成功研發(fā)出多款干細(xì)胞產(chǎn)品,并在心血管、燒傷等領(lǐng)域取得了顯著的臨床效果。Cytori Therapeutics在干細(xì)胞治療領(lǐng)域的領(lǐng)先地位,使其成為全球干細(xì)胞產(chǎn)業(yè)的重要參與者。
綜上所述,通策醫(yī)療、華潤三九、中源協(xié)和以及國際干細(xì)胞療法公司等在干細(xì)胞領(lǐng)域具有較高知名度和競爭力。然而,干細(xì)胞行業(yè)仍處于快速發(fā)展階段,未來市場競爭格局可能會有所變化。哪家公司能夠脫穎而出,成為干細(xì)胞領(lǐng)域的領(lǐng)軍企業(yè),還需時間和市場的檢驗(yàn)。
- 2024-10-21干細(xì)胞輸注能根治膿毒癥嗎,間充質(zhì)干細(xì)胞或可成為治療膿毒癥的殺手锏
- 2024-08-26造血干細(xì)胞是骨髓嗎,造血干細(xì)胞與骨髓區(qū)別
- 2024-11-06移植干細(xì)胞最新研究進(jìn)展與突破是什么?
- 2024-08-27造血干細(xì)胞捐獻(xiàn)危害,對身體有影響
- 2024-10-18蘋果干細(xì)胞的副作用,蘋果干細(xì)胞的功效與作用
- 2024-10-26心皮膚干細(xì)胞作用與功效有哪些?
- 2024-09-10干細(xì)胞生產(chǎn)企業(yè)排名,干細(xì)胞十大公司排名及價格
- 2024-08-07干細(xì)胞免疫療法,干細(xì)胞免疫療法可以治療哪些病癥
- 2024-07-17干細(xì)胞對糖尿病腎病有用嗎,干細(xì)胞治療糖尿病腎病應(yīng)用前景廣闊
- 2024-10-10重慶干細(xì)胞移植費(fèi)用高嗎?影響因素解析
- 2024-10-01干細(xì)胞抗衰老真的有效嗎,干細(xì)胞抗衰是如何實(shí)現(xiàn)的
- 2024-09-13山東莒縣捐贈干細(xì)胞機(jī)構(gòu)有哪些,內(nèi)附名單表
- 2024-10-02卵巢早衰干細(xì)胞治療效果如何,有哪些疑問需注意
- 2024-08-05干細(xì)胞治療費(fèi)用,干細(xì)胞治療的風(fēng)險大嗎
- 2024-07-31自體脂肪干細(xì)胞效果,自體脂肪干細(xì)胞的作用和功效
- 2024-09-07廣州干細(xì)胞存儲結(jié)構(gòu)研究中心,廣州干細(xì)胞醫(yī)院有哪家
- 2024-10-11干細(xì)胞療法適合哪些病癥?效果真的那么神奇?
- 2024-08-02干細(xì)胞治療骨關(guān)節(jié)炎,干細(xì)胞治療骨關(guān)節(jié)炎的原理
